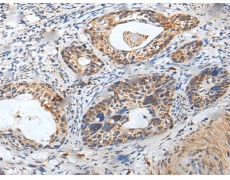
一抗

中文名稱:兔抗ZPBP多克隆抗體
|
Background: |
ZPBP is one of several proteins that are thought to participate in secondary binding between acrosome-reacted sperm and the egg-specific extracellular matrix, the zona pellucida (McLeskey et al., 1998 [PubMed 9378618]). May be implicated in gamete interaction during fertilization. |
|
Applications: |
ELISA, WB, IHC |
|
Name of antibody: |
ZPBP |
|
Immunogen: |
Fusion protein of human ZPBP |
|
Full name: |
zona pellucida binding protein |
|
Synonyms: |
ZPBP1 |
|
SwissProt: |
Q9BS86 |
|
ELISA Recommended dilution: |
5000-10000 |
|
IHC positive control: |
Human brain |
|
IHC Recommend dilution: |
25-100 |
|
WB Predicted band size: |
40 kDa |
|
WB Positive control: |
Human testis tissue lysate |
|
WB Recommended dilution: |
200-1000 |



 購物車
購物車 幫助
幫助
 021-54845833/15800441009
021-54845833/15800441009